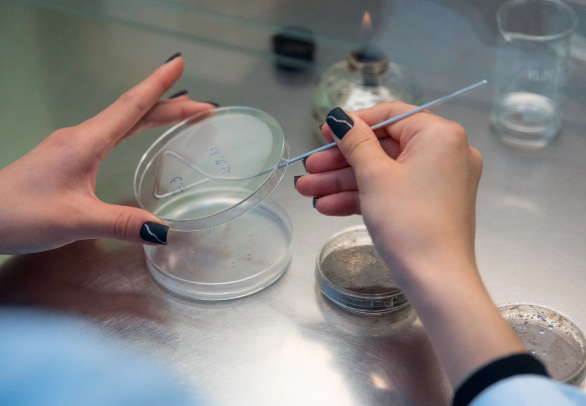

Доход от научных разработок ДВФУ впервые превысил 1,4 млрд рублей
Значительную часть этих средств инвестируют в развитие научной инфраструктуры и стимулирование ученых

Значительную часть этих средств инвестируют в развитие научной инфраструктуры и стимулирование ученых